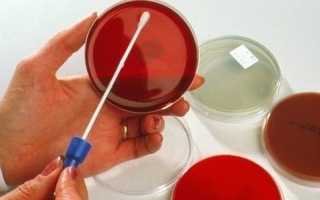

Не всем известно, что уретритом также как мужчины могут заболеть и женщины. Оба пола болеют этим заболеванием в равной степени, но диагностируется у мужчин он чаще, потому, что симптомы более выражены. У женщин симптомы иногда имеют невыраженный характер или даже отсутствуют. Несвоевременное диагностирование болезни приводит к переходу ее в хроническую стадию.
Статьи по теме:
-
Уретрит у женщин — симптомы, причины и лечение -
Быстро лечим уретрит в домашних условиях -
Симптомы и лечение уретрита у мужчин -
Лечим мужской уретрит при помощи препаратов -
Лечим цистит у детей дома в минимальные сроки
Важно! Уретрит может сопровождать какое-либо другое сложное заболевание мочеполовой системы. Поэтому, чтобы не откладывать начало лечения, при самых незначительных симптомах уретрита следует обратиться к врачу.
Анатомия строения женской уретры способствует проникновению в мочеиспускательный канал и мочевой пузырь возбудителей этого заболевания. Достаточно широкий мочеиспускательный канал позволяет даже при его отеке не нарушать процесс оттока мочи.
Причины заболевания
Это заболевание не способно причинить угрозу жизни, но его осложнения могут быть опасны для организма женщины. Так, одним из осложнений уретрита у женщин является цистит. Уретрит вызывает неприятные ощущения и лишает комфорта. Основными причинами возникновения уретрита могут быть инфекции, но также он может иметь и неинфекционный характер. После диагностирования врачами заболевания, определяется характер и длительность проводимого лечения.
Диагностика
Для диагностики проводится целый ряд исследований
Диагностика уретрита проходит в несколько этапов, они включают в себя следующее:
- Опрос пациента, а также анализ полученной информации. Специалист интересуется, что беспокоит пациента, когда были замечены первые симптомы, а также когда был последний половой акт.
- Урологический осмотр – проводит гинеколог или уролог. Осматривается уретра, а также характер присутствующих выделений – скудные или обильные, с запахом или без, вязкие они или жидкие. Следует осмотреть наружные половые органы, нет ли на них эрозий, сыпи, налета и прочее.
- Берется мазок из уретры, отправляется на посев в питательную среду, проводится исследование клеточного состава под микроскопом. При развитии трихомонадного уретрита в свежих выделениях можно увидеть активно двигающиеся жгутики.
- Уретроскопия – это инструментальный метод обследования. Тонкий зонд с волоконными световодами вводится в уретру, это позволяет рассмотреть стенки канала, а также степень его сужения. В острой фазе заболевания проводить подобное обследование запрещается.
- Уретрография – в уретру вводится рентген-контрастное вещество, после чего проводится рентген исследование.
- Традиционные анализы. Берется биохимический анализ, общий анализ крови, анализ мочи.
- ПЦР диагностика – это быстрый и точный метод исследования.
- Ультразвуковое обследование органов малого таза – у женщин контролируется состояние яичников, матки и мочевого пузыря, у мужчин – семенные пузырьки, предстательная железа, мочевой пузырь.
После оценки всех данных от пройденного обследования ставится диагноз. Лечение назначается индивидуально для каждого пациента, с учетом стадии развития заболевания, возраста и прочего.
Лечение
Острый уретрит, протекающий без каких-либо осложнений можно лечить амбулаторно, без пребывания в стационаре. Полное выздоровление женщины происходит при регулярном приеме назначенных препаратов. Врач поликлиники наблюдает за ходом выздоровления. Лечение происходит путем терапии антибиотиками. При этом следует тщательно подойти к выбору антибиотика. Вирус, который спровоцировал уретрит, должен быть чувствителен к назначенному препарату.
В зависимости от причины возникновения заболевания могут быть использованы такие антибиотики:
- При неспецифическом уретрите: сульфазол, уросульфан, азитромицин, кларитромицин, клинафлоксацин, цефазолин, цефотаксим, цефтриаксон.
- Для лечения гонококкового уретрита: спектиномицин, олететрин, эритромицин, цефтриаксон, цефуроксим, рифампицин ,цефакор и другие препараты, оказывающие действие на хламидий.
- Если уретрит имеет трихомонадное происхождение: трихопол, бензидамин, иморазол, орнидазол, хлоргексидин, свечи йодовидон.
- Уретрит кандиозный лечится применением: нистатина, натамицина , амфоглюкамина, клотримазола, леворина,
- При микоплазменном уретрите: тетрациклин и другие антибиотики из его группы,
- Хладимидый уретрит поддается лечению препаратами: эритромицин, кларитромицин, тетрациклин, доксициклин, азитромицин, клинафлоксацин.
- Если уретрит вызван вирусами: рибавирин, фамцикловир, ганцикловир, ацикловир пенцикловир и др.
Схема лечения вагинальными таблетками трихопол
Препарат можно приобрести в аптеке в виде таблеток, свечей для вагинального применения или в виде инъекционного раствора. Он может назначаться во время беременности, начиная с двенадцатой недели. Антивирусное действие трихопола основано на возможности проникновения его действующего вещества внутрь бактерий и разрушения ДНК с последующей их гибелью.
Таблетки трихопола могут быть назначены и детям от трех лет. Назначение разным возрастным категориям в таком количестве:
- детям от 3-х до 7-ми лет — 1 /2 таблетки два раза в сутки;
- детям от 7-ми до 10-ти лет – 1 /2 таблетки трижды в сутки;
- взрослым – 1 таблетка трижды в сутки.
Если заболевание не вызвало осложнений, то курс лечения трихополом составляет 7 дней.
Трихопол в виде инъекций может быть назначен в таком количестве:
- до 12 летнего возраста – 7,5 мг на каждый килограмм веса ребенка (перерыв между инъекциями должен составлять 8 часов);
- взрослым – 100 мл препарата 3 раза в сутки (интервал через 8 часов).
Продолжительность, при инъекционном воздействии на бактерии, составляет 1 неделю. Если состояние пациента не стабилизировалось полностью за это время, то его переводят на прием таблеток.
Применения свечей трихопола назначается по 1 разу в сутки. Более эффективное действие свечей, введенных перед сном. Период лечения свечами определяется врачом, но обычно от 7 до 10 дней после окончания месячных.
Важно! Но, если болезненное состояние пациентки тяжелое, то лечения свечами проводят и в период месячных.
Профилактика
Главное правило профилактики – использование средств контрацепции
Для того чтобы избежать развития заболевания и не допустить его рецидива после лечения, следует выполнять простые рекомендации:
- При половом контакте следует пользоваться средствами контрацепции.
- Следует соблюдать правила личной гигиены. Если половой акт без презерватива имел место быть, следует сразу же сходить в туалет и помыть половые органы большим количеством воды с жидким мылом. В первые два часа после этого рекомендуется обработать половые органы раствором-антисептиком.
- Ни в коем случае нельзя допускать переохлаждения.
- Несколько раз в год следует посещать больницу и проходить профилактический осмотр.
- Вступать в половые контакты с малознакомыми людьми нельзя.
Более подробная инструкция по ведению правильного образа жизни выдается врачом. Следует помнить, что отсутствующее лечение может привести к многочисленным последствиям, а лечить их гораздо сложнее, чем само заболевание.
Уретрит у беременных
Беременным не следует пренебрегать лечением уретрита. Если вы заметили, что мочеиспускание доставляет вам болевые ощущения, которые не прекращаются после мочеиспускания, следует обратиться к врачу, чтобы он определил причину возникновения этого заболевания и назначил лечение.
Уретрит у беременных на ранних сроках
Инъекционный уретрит особенно в начальной стадии беременности негативно может сказать на ребенке. Потому что он, возможно, станет причиной более серьезных воспалительных процессов мочеполовой системы, а также патологий развития ребенка. Многие лекарства на ранних стадиях беременности нежелательны. Поэтому схему лечение должен определять только врач.
Лечение уретрита у беременных — препараты
Лечение уретрита, даже если он не имеет инфекционной формы, лечится с применением антибиотиков. Неинфекционный уретрит менее опасен, но, все же, требует лечения. При этом препараты для лечения подбираются более щадящие для плода. Иногда назначается местная терапия и курс лечения для повышения иммунитета женщины.
Беременным назначаются препараты:
- амоксициллин, эритромицин и джозамицин при хламидиозной инфекции;
- цефтриаксон, спектиномицин, цефиксим при уретрите спровоцированном гонореей;
- джозамицин, когда заболевание начинается из-за начавшегося уреаплазмоза и микоплазмоза.
Более щадящее лечение для беременных — лечение народными средствами (настойки и отвары). Но не стоит слишком надеяться на народные средства. А также не назначайте себе самостоятельно лечение антибиотиками. Эти две крайности могут неблагоприятно отразиться на развитии ребенка.
Лечение без антибиотиков
Если вы категорически не желаете принимать антибиотики, то уретрит можно лечить, например, с помощью гирудотерапии. Применение медицинских пиявок при этом заболевании позволяет снять воспаление и восстановить иммунитет, который был ослаблен в процессе заболевания.
Лечение пиявками должно проводиться под наблюдением врача-уролога. Пиявки прикладываются на кожу по проекции мочеиспускательных каналов (от области паха до поясницы). В этих местах находятся рефлексогенные зоны.
Для лечения уретрита достаточно проведения 6-8 сеансов. Перерыв между проведением сеансов достаточно сделать 2 или 3 дня. За проведенный курс лечения восстанавливается функция мочеточников, а также стимулируется эффективность их действия.
Внимание! Вы можете прочитать про недержание мочи в нашей подробной статье.
Клотримазол
Назначается клотримазол при кандиозном уретрите в таком виде:
- вагинальные таблетки;
- крем для вагинального применения;
- гель вагинальный.
Таблетки вагинальные вводятся глубоко во влагалище. Количество препарата и срок лечения определяется врачом. Обычно это делается один раз дозой в 500 мг, или лечение на протяжении трех дней по 200 мг, а также недельный срок лечения по 100 мг. Раствором клотримазола лечение проводится путем введения его в уретру капельным способом.
Важно! Противопоказания к его применению могут быть из-за повышенной чувствительности к препарату, проведение лечения во время месячных и беременных первых трех месяцев.
Азитромицин
Действующее вещество антибиотика проникает внутрь клетки, подавляя РНК-зависимый синтез белка у микроорганизмов. Его с успехом используют как отечественные, так и зарубежные европейские врачи.
Азитромицин зарекомендовал достаточно эффективным средством в лечении уретрита. При лечении этим препаратом не требуются какие-либо другие дополнительные средства, что оказывает более щадящее действие на организм женщины. Препарат быстро всасывается тканями их ЖКХ.
Дозировку определяет врач и обычно продолжительность лечения этим лекарством составляет от двух до пяти дней. Азитромицин принимается один раз в сутки:
- для взрослых устанавливается доза от 0,25 до 1 г в сутки;
- детям от 5 до 10 мг на 1 кг веса 1 раз в день.
Он может взаимодействовать с другими принимаемыми в этот момент лекарствами и вызывать побочные явления. Поэтому при его приеме требуется взвешенный подход к комбинации с другими препаратами. Беременным препарат назначает в исключительных случаях, а при нарушениях работы печени препарат не назначается.
Ципрофлоксацин
Антибиотик имеет большой спектр действия. Назначается при уретрите как основной лечебный препарат, хорошо впитывается из ЖКТ. Выпускается в форме таблеток, а также в виде раствора для инъекций. Ципрофлоксацин не назначают детям возрастом до 18 лет, беременным женщинам и в период лактации. Действие препарата может негативно сказаться на нервной системе пациента, вызвать состояние депрессии, галлюцинаций и бессонницы. Могут быть нарушения в работе желудочно-кишечного тракта.
Важно! Нужно отказать от вождения автомобиля и от работ, которые требует повышенного внимания.
- Доза, в которой препарат назначается, составляет 0,125 — 0,5 г для приема дважды в день. В тяжелых случаях препарат назначается в больших дозах.
- Длительность проводимого препаратом лечения может длиться до полумесяца. Инъекции назначаются внутривенно по 0,1 г. дважды в сутки.
- После облегчения состояния больного ципрофлоксацин назначается в форме таблеток.
Препарат хорошо переносится, и лишь в некоторых случаях могут возникнуть побочные явления. При лечении препаратом не следует находиться под солнечными лучами. Противопоказано детям до пятнадцатилетнего возраста, кормящим материя и беременным женщинам.
Канефрон
В дополнение к антибиотикам назначаются препараты растительного происхождения. Канефрон принадлежит к таким средствам. Он оказывает мочегонное и обеззараживающее действие. А также обезболивает. Но один этот препарат не имеет возможности избавить от уретрита.
Препарат практически не имеет противопоказаний. Его назначают и беременным и кормящим женщинам. Также он назначается детям. Но, все же, принимать его следует по назначению врача.
Важно! Принимая канефрон в форме таблеток, их необходимо заглатывать целиком без разжевывания в ротовой полости или предварительного измельчения.
Взрослым пациентам препарат назначается по 2 таблетки трижды в день, а детям старше 6 лет по 1 таблетки с таким же количеством приемов в день. Детям, не достигшим шестилетнего возраста, можно назначать его в виде капель.
Фурамаг
Препарат содержит противомикробные вещества, которые действуют как противовоспалительное средство. Выпускается в таблетках, капсулах и суспензии, предназначенной для приготовления растворов.
- Следует соблюдать дозировку, определенную лечащим врачом. Передозировка препарата может вызвать аллергические реакции.
- Обычная доза взрослым – 100 мг в день. Запивается большим количеством воды.
- Лечение препаратом до 15 дней.
Внимательно назначается препарат при одновременном лечении с другими препаратами. А также при лечении противопоказано принимать алкоголь.
Бисептол
Этот препарат не принадлежит к группе антибиотиков, но способен справиться с бактериями, возбудителями воспалений. Но он воздействует не на все виды микроорганизмов. Но в некоторых случаях бисептол способен вылечить уретрит.
- Бисептол при уретрите принимается в виде таблеток трижды в день после принятия пищи.
- Обычный период лечения бисептолом 5 дней.
Противопоказан беременным и кормящим женщинам, пациентам, имеющим проблемы с почками и системой образования крови, а также престарелые люди должны принимать этот препарат под наблюдением врача.
Бактериофаги
Возможно, что в будущем бактериофаги займут приоритетное место среди лечебных препаратов уретрита. Стаффилококовый бактириофаг способен уничтожить до 90 процентов стафиллакоков при гнойных заболеваниях. Это оптимальное лечение для новорожденных детей, и в любом случае – это лучше чем лечение антибиотиками.
- При лечении уретрита бактериофаг применяется в виде ректальных свечей или вводится в виде раствора через катетер.
- Лечение проводится сроком от 7 дней до трех недель. Курсы лечения повторяются трижды после перерыва в 3 дня.
Что такое уретра и где она находится
Уретра – это мочеиспускательный канал, представляющий собой прямую трубку длиной 3-5 см. Женская уретра короче и шире мужской, а также имеет более простую форму. Она окружена соединительной тканей, мышечной и слизистой оболочкой.
Мочеиспускательный канал имеет форму воронки, в нём присутствует расширение возле мочевого пузыря, которое уменьшается к наружному отверстию. В слизистой оболочке присутствует призматический эпителий, образующий несколько складок, в том числе и гребень мочеиспускательного канала.
Как выглядит строение уретры, можно посмотреть на фото.
Расположение уретры в женском организме
Расположение уретры параллельно влагалищу: мочеиспускательный канал срастается с передней стенкой влагалища и расположен перед ним. Канал проходит через мышцы, расположенные в тазовом дне. Ближе к наружной части мышечный тонус вокруг уретры ослабляется.
Важно!Травмирование или инфицирование уретры вызывает уретрит – воспаление мочеиспускательного канала, также известное как уретральный синдром.
Лечение травами
Для облегчения состояния женщин при уретрите можно воспользоваться рецептами народной медицины с применением лекарственных трав. Существует много таких рецептов.
Например, можно воспользоваться отваром из набора трав: крапива, мята, аир, хвощ полевой, шиповник и плоды можжевельника.
- 2 ст. л. смеси из равного количества этих трав заливаются 500 мл воды, и кипятится на протяжении 20 минут.
- Пить необходимо по 1 стакану отвара перед сном.
Убрать неприятные ощущения можно липовым отваром. Готовится он путем кипячения 2 ст. л. цветков липы в 2 литрах воды. После 10 минутного кипячения и остывания отвар процеживается. Пить по 125 г перед сном.